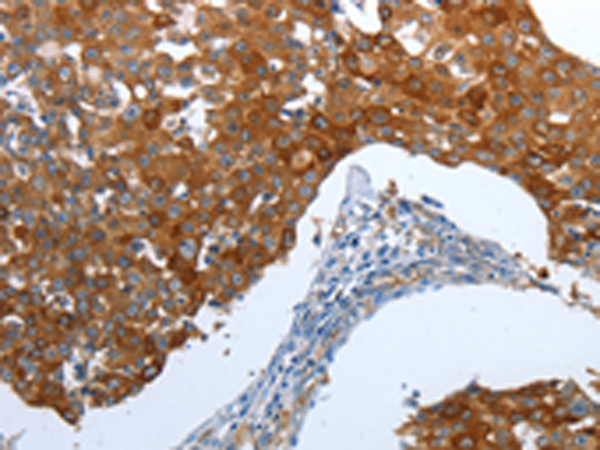

中文名稱:兔抗CEACAM5多克隆抗體
英文名稱: Anti-CEACAM5 rabbit polyclonal antibody
別 名: CEA, CD66e
相關類別: 一抗
儲 存: 冷凍(-20℃)
抗 原: CEACAM5
宿 主: Rabbit
反應種屬: Human
標 記 物: Unconjugate
克隆類型: rabbit polyclonal
技術規(guī)格
|
Background: |
Members of the CEACAM subfamily, including CEACAM5, belong to the CEA gene family. For general information on the CEA gene family, see CEACAM1. Cell surface glycoprotein that plays a role in cell adhesion and in intracellular signaling. Receptor for E.coli Dr adhesins. Found in adenocarcinomas of endodermally derived digestive system epithelium and fetal colon. |
|
Applications: |
ELISA, IHC |
|
Name of antibody: |
CEACAM5 |
|
Immunogen: |
Synthetic peptide of human CEACAM5 |
|
Full name: |
Carcinoembryonic antigen-related cell adhesion molecule 5 |
|
Synonyms: |
CEA, CD66e |
|
SwissProt: |
P06731 |
|
ELISA Recommended dilution: |
1000-5000 |
|
IHC positive control: |
Human breast cancer and Human thyroid cancer |
|
IHC Recommend dilution: |
25-100 |
購物車
幫助
021-54845833/15800441009
